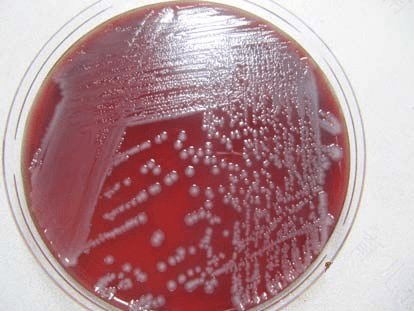
白色念珠菌是厌氧菌吗? 白色念珠菌是厌氧菌吗?

白色念珠菌感染多表现为阴道炎症或者口腔方面的炎症,它属于真菌的一种,本身不会使机体致病,但如果肠道内的菌群失调或者呼吸道的菌群失调,都可能会使细菌进行繁殖而致病。如果不及时的进行处理,可能会导致白色念珠菌感染症状加重。那么白色念珠菌是厌氧菌吗?
白色念珠菌不是厌氧菌,是需氧菌。它多发生于长期的使用抗生素类药物而导致的,因为抗生素会导致阴道内的正常菌群被破坏,从而失去了对阴道的保护作用,所以女性朋友在平时用药时一定要慎重,避免不当的药物使用导致身体方面疾病的发生。而且要多注意规律自己的性生活,避免多个性伴侣导致机体的炎症增大,妇科疾病的发生。
另外,女性朋友们平时要避免着穿不透气的化纤内裤和使用不合格的卫生巾,这都是导致细菌传播的主要途径。而且内裤在洗涤后一定要在太阳下暴晒,阴暗且潮湿的条件,都可能会使白色念珠菌滋生造成妇科炎症的感染。每天坚持用温水对外阴进行清洁,避免过多的使用冲洗液而使阴道内的酸碱平衡度被破坏。
标签:
